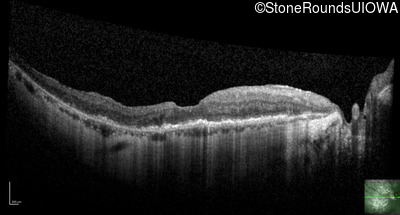
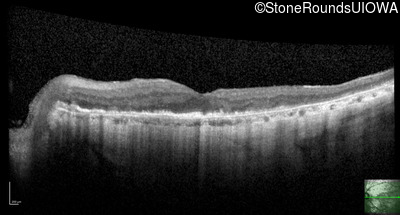
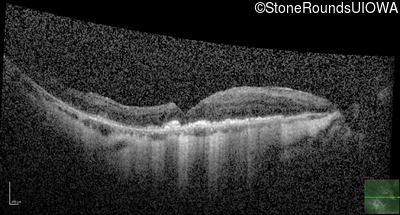
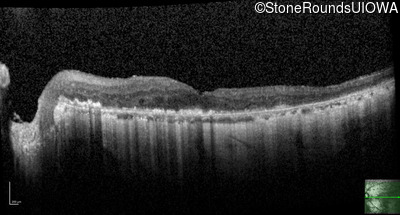
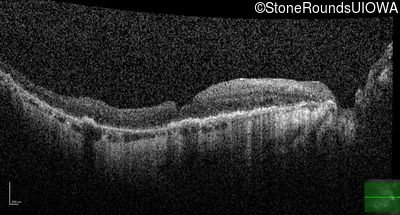
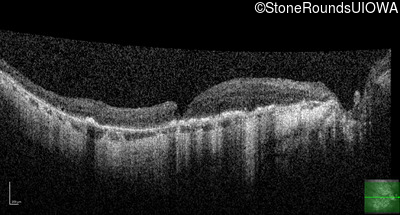
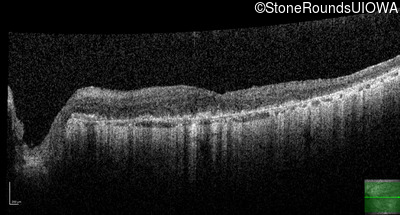
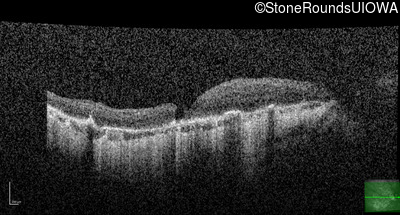
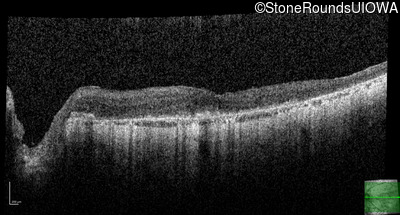
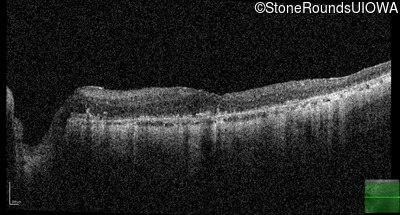

Case
SR2196
Student Mode
Late Onset Retinal Dystrophy (IIIA3)
Male
Male
Hidden
SR2196
Student Mode
Late Onset Retinal Dystrophy (IIIA3)
Male
Male
History
This 81 year old man began using a flashlight to read menus in his 40's. At age 75 his ophthalmologist noticed abnormal fundus findings and referred him to a retina specialist.
| Age at visit: 81 years |
| Age at visit: 82 years |
| Age at visit: 83 years |
| Age at visit: 84 years |
| Age at visit: 85+ (Visit 1) |
| Age at visit: 85+ (Visit 2) |
| OD | OS | ||
|---|---|---|---|
Diagnosis & molecular findings
| Disease | Gene | Allele 1 variant(s) | Allele 2 variant(s) | Inheritance mode |
|---|---|---|---|---|
| Late Onset Retinal Dystrophy | C1QTNF5 | Ser163Arg AGC>AGA | AD |
Disease:
Gene:
Allele 1:
Ser163Arg AGC>AGA
Allele 2:
Inheritance:
AD